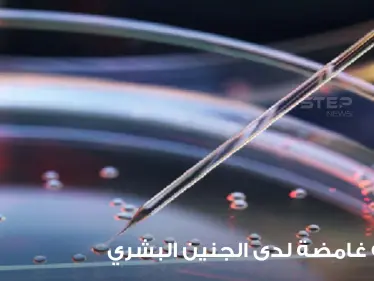
دراسة قد "تغير التاريخ".. علماء يكتشفون مرحلة "غامضة" لدى الجنين البشري ويوضحون التفاصيل - وكالة ستيب نيوز

- قصة اغتيال جون كينيدي
هزت حادثة اغتيال كينيدي العالم أجمع حيث أُطلق الرصاص عليه وهو في سيارة مكشوفة خلال (جريمة) غامضة لم تبح بأسرارها حتى اللحظة.في تفاصيل الواقعة، تم اغتيال الرئيس الخامس والثلاثون للولايات المتحدة الأمريكية، جون كينيدي في يوم الجمعة الموافق 22 نوفمبر 1963 في دالاس، عندما كان كينيدي يستقل مع زوجته جاكلين وحاكم تكساس جون كونالي وزوجته نيللي سيارة مكشوفة في شوارع مدينة دالاس.وبمجرد أن عبر موكب كينيدي بسرعة منخفضة في وسط المدينة وخلال مرور السيارة الرئاسية على ديلي بلازا، جرى إصابته بطلقات نارية قاتلة من قبل جندي مشاة البحرية الأمريكية السابق "لي هارفي أوزوالد" الذي أطلق النار من كمين في مبنى قريب، فيما أصيب الحاكم كونالي بجروح خطيرة في الهجوم.4K化・60fps化されたザプルーダー・フィルム。 ザプルーダー・フィルムは、1963年11月22日にジョン・F・ケネディ大統領がテキサス州ダラスで銃撃された瞬間を捉えたカラーフィルム。撮影したのは、ダラスの婦人服製造業者エイブラハム・ザプルーダー。 こちらの動画は1080pです。閲覧注意。 pic.twitter.com/FnhhlFVweV
— 中井寛一 (@ichikawakon) November 22, 2021